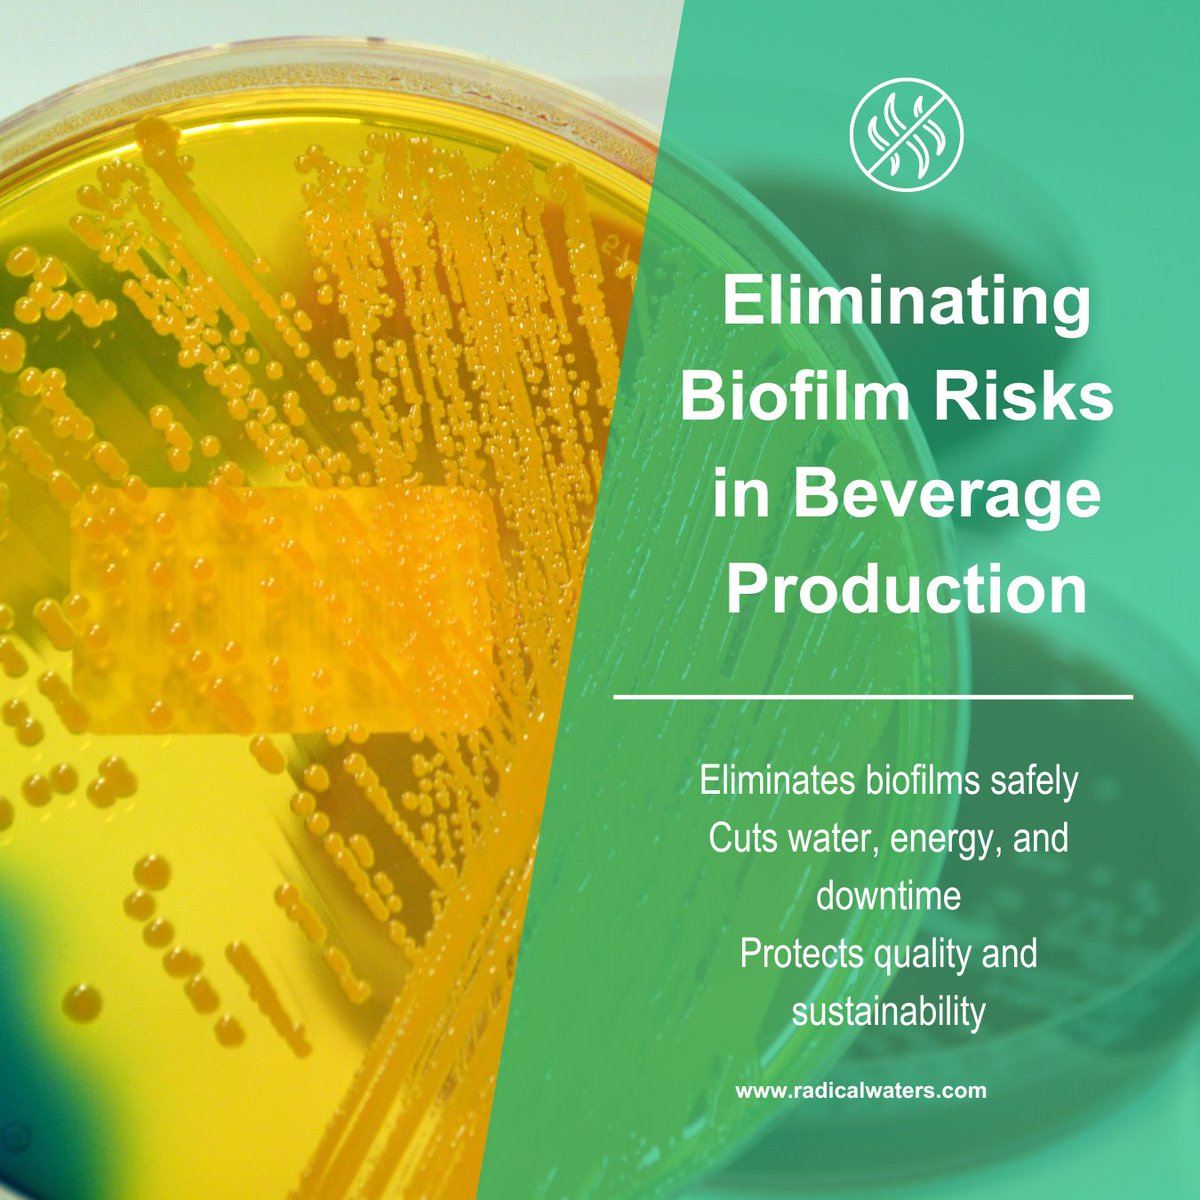
Biofilms are a costly risk in beverage production - resistant, persistent, and a threat to food safety.

Radical Waters’ ECA technology removes biofilms at the source with on-site, chemical-free solutions.

Safer hygiene. Lower costs. Real sustainability.

#FoodSafetyCompliance

Radical Waters
@radicalwaters
#RadicalWaters has successfully been replacing chemicals and other traditional disinfectants with Hypochlorous Acid (HOCl), also known as #Anolyte or #ECA water
ID: 110355233
http://www.radicalwaters.com 01-02-2010 07:25:47
713 Tweet
140 Followers
119 Following














Salt + Water + Electricity = The Future of Food Safety. Conventional chemicals are becoming a thing of the past. The future is ECA (Electro-Chemical Activation). Safe, sustainable, and effective. That’s the Radical Waters way. 🌍💧 #ECA #RadicalWaters #FoodTech #sustainable


Season’s Greetings from Radical Waters! May this festive season bring you rest, reflection, and renewed energy for the year ahead. Together, we look forward to another year of innovation, progress, and purpose. Please email [email protected] during this time